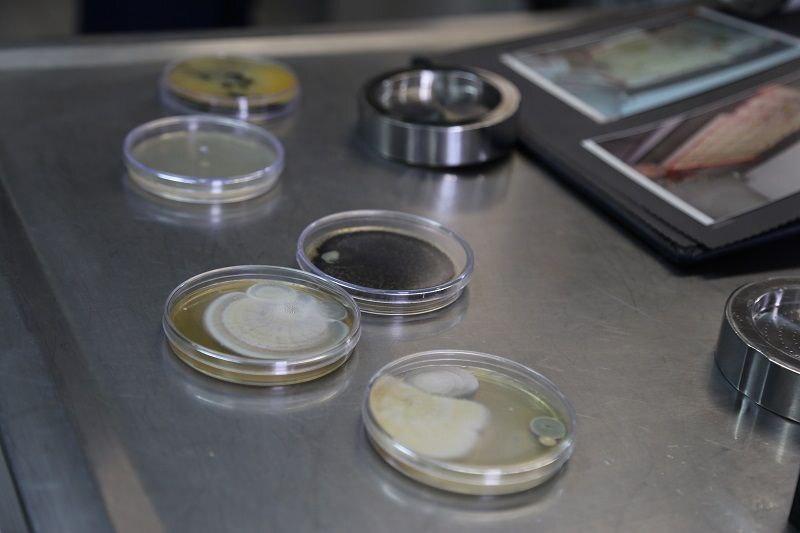
عکس

بازدید دانشجویان دانشگاه علامه طباطبائی از سازمان اسناد و کتابخانه ملی ایران

عطنا- جمعی از دانشجویان رشته روابط عمومی دانشکده علوم ارتباطات دانشگاه علامه طباطبائی به منظور آشنایی با ساختار، وظایف و خدمات مرکز آرشیو، صبح دوشنبه ۵ خرداد ماه ۱۴۰۴، از سازمان اسناد و کتابخانه ملی جمهوری اسلامی ایران دیدن کردند.
این بازدید همچنین با هدف آشنایی با فعالیتها، ظرفیتها و پروژههای جاری این سازمان انجام شد.
در ابتدای بازدید کارشناسان سازمان به ارائه توضیحات اولیه درباره تاریخچه شکلگیری سازمان طراحی و استفاده از فضای ساختمانی در بخشهای گوناگون و مأموریتهای اصلی آن شامل جمعآوری، نگهداری و حفاظت از اسناد ملی کشور پرداخت و پس از آن دانشجویان از بخشهای مختلف آرشیو ملی بازدید کردند.
دانشجویان با حضور در بخشهای مختلف سازمان از جمله تالارهای نگهداری اسناد، مرکز دیجیتالسازی و بخش مرمت اسناد، از نزدیک با روند نگهداری، حفاظت و دسترسی به اسناد ملی، آشنا شدند.
همچنین این بازدید فرصتی ارزشمند برای آشنایی عینی با فرآیندهای حرفهای در حوزه آرشیو و اسناد بود و موجب ارتقای درک دانشجویان از جایگاه اسناد در نظام اطلاعاتی کشور و تشویق آنان به پژوهش بیشتر در این حوزه شد.
عکاس: عطیه انصاری

نظر شما :